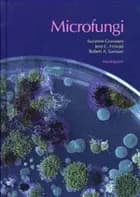
Microfungi af Suzanne Gravesen, Jens C. Frisvad og Robert A. Samson

Microfungi
af Suzanne Gravesen, Jens C. Frisvad, & Robert A. Samson
Indbundet bog, 168 sider
ISBN: 9788716114365
Udgivet 01-01-1970 af Handelshøjskolens Forlag
Vi er endnu ikke stødt på en boganmeldelse af 'Microfungi' i de 527 aviser, blogs og andre medier, vi har fulgt siden 2010. Men vi har fundet 117.366 andre anmeldelser af bøger.